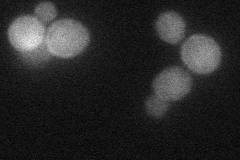
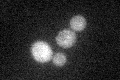

View description
Phospholipase D, catalyzes the hydrolysis of phosphatidylcholine, producing choline and phosphatidic acid; involved in Sec14p-independent secretion; required for meiosis and spore formation; differently regulated in secretion and meiosis
Localization:
Intensity:
Fold change:
Significance:
-
C’ GFP library in SD

cytosol24.39 -
N' NOP1pr-GFP in SD

cytosol61.2917 -
N' TEF2pr-mCherry in SD
cytosol,cell periphery23.7917 -
N' NATIVEpr-GFP in SD

below threshold23.0245 -
N' TEF2pr-VC and Cyto-VN in SD

cytosol30.6063 -
C’ GFP library in SD+DTT
cytosol21.580.88No -
C’ GFP library in SD+H2O2

cytosol26.671.09No -
C’ GFP library in Starvation Media

cytosol21.580.88No -
C’ GFP library on the background of Pup2-DaMP

cytosol -
C’ GFP library on the background of CCT mutant

cytosol27.66861.13406No
